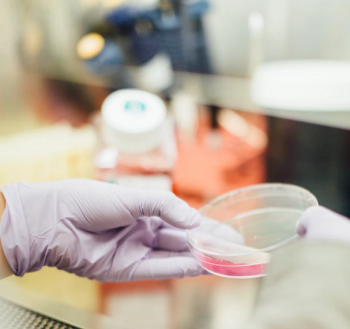

First responders are twice as likely to become infected with COVID-19 in the workplace as health care workers and other essential workers, and this increases significantly after adjusting for cofounding factors.
Nina Cosdon is the associate editor for Contagion. Before joining MJH Life Sciences, she graduated magna cum laude from Denison University in 2021 with a degree in Communication. You can find her reading, hiking, or antiquing, or by emailing her at ncosdon@mjhlifesciences.com.

First responders are twice as likely to become infected with COVID-19 in the workplace as health care workers and other essential workers, and this increases significantly after adjusting for cofounding factors.

Carbapenem-resistant Klebsiellae was 92.5% susceptible to a combination of ceftibuten (CTB) and VNRX-5236.

Healthcare providers are less likely to prescribe HIV PrEP to Black women, largely due to behavioral stereotyping.

The median vaccination rate of white American adults was found to be 1.3 times higher than Black and Hispanic adults.

A study presented advocated for combining taniborbactam and cefepime to treat P aeruginosa isolates that develop ESAC phenotypes.

Data presented to the Vaccines and Related Biological Products Advisory Committee (VRBPAC) showed 2 10 µg doses of the Pfizer-BioNTech vaccine to be 90.7% effective in children older than 5 and younger than 12.

The Centers for Disease Control and Prevention (CDC) Director Rochelle Walensky's, MD, endorsement Thursday evening came after 2 days of deliberation from the CDC’s Advisory Committee on Immunization Practices (ACIP) where the group recommended the Moderna and Janssen COVID-19 vaccine “booster” doses.

The CDC’s Advisory Committee on Immunization Practices (ACIP) updated their pneumococcal vaccination recommendations, adding Merck’s sequential vaccine regimen.

The actions taken by the FDA set differing availability of the 3 emergency-authorized vaccines.

Higher use of 7 major antibiotics in hospitals is corelated with higher rates of Clostridioides difficile infection.

The CDC found 2 doses of Pfizer-BioNTech reduced COVID-19 severe outcomes and hospitalization by 93% in adolescents 12-18 years old.

In a phase 3 trial, sulbactam-durlobactam (SUL-DUR) was found to more favorably treat carbapenem-resistant Acinetobacter baumannii (CRAB) than colistin.

Infants, children, and adolescents can carry and spread COVID-19 at the same rate as adults.

Children living with HIV have a new once-daily treatment option to maintain virologic suppression.

The VRBPAC committee unanimously voted in favor of the Janssen (Johnson & Johnson) COVID-19 vaccine for use under EUA as a booster dose in individuals 18 years and older at least 2 months after a single dose primary vaccination.
In a recent study, taniborbactam restored in vitro activity of cefepime against Enterobacterales.

While receiving a booster of one’s original COVID-19 shot leads to an immune boost, this was heightened among individuals who received a different booster than their primary vaccine.

The FDA suggested that Johnson & Johnson had not conducted an appropriately thorough test to prove its vaccine requires a six-month booster.

People who inject drugs in rural areas had a less accurate understanding of HIV PrEP, largely due to stigma surrounding sexual orientation and drug use.

A recent study by the CDC found that HIV PrEP awareness and referrals are lower among Hispanic persons than non-Hispanic white persons.

In the recent TACKLE phase 3 trial, AZD7442 significantly reduced the risk of developing severe COVID-19 or death, even among high-risk populations.

If the FDA approves maribavir, it will be the first and only treatment for adults with CMV as a result of a hematopoietic stem cell transplant or solid organ transplant.

A global study of C. difficile isolates worldwide found a very high prevalence of the bacteria on shoe soles.

A recent study measured premature deaths among people with HIV by sex, race, and HIV risk factor.

Qatar has the highest mRNA vaccine coverage in the world, but their vaccinated population is experiencing significant waning in vaccine efficacy, leading to breakthrough infections.

Malaria has afflicted humanity for thousands of years, and the parasite is especially deadly for children and babies. The WHO has recommended the first malaria vaccine be deployed across sub-Saharan Africa.

This investigational therapy could be the first implantable form of PrEP.

AstraZeneca’s long-acting antibody, AZD7442, would act as a supplement to vaccination and could provide up to a year of protection against symptomatic COVID-19.

People who inject drugs are at high-risk for HIV infection, but very few are interested in PrEP prescriptions.

This study confirmed reports from the CDC and Israel Ministry of Health that found the Pfizer-BioNTech vaccine waned after 6 months.